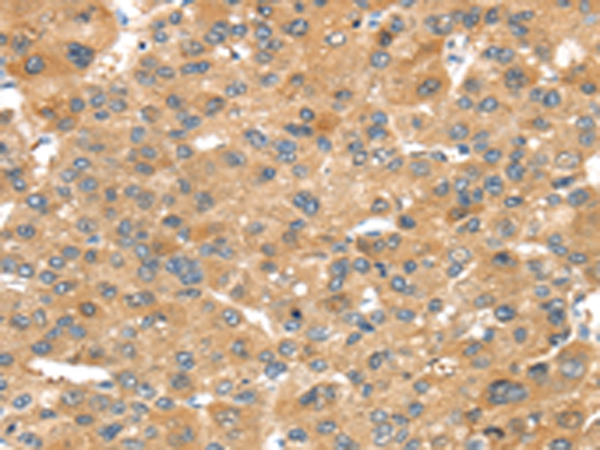
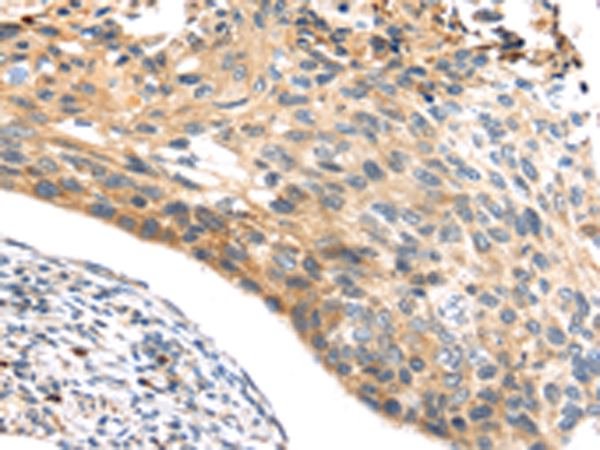
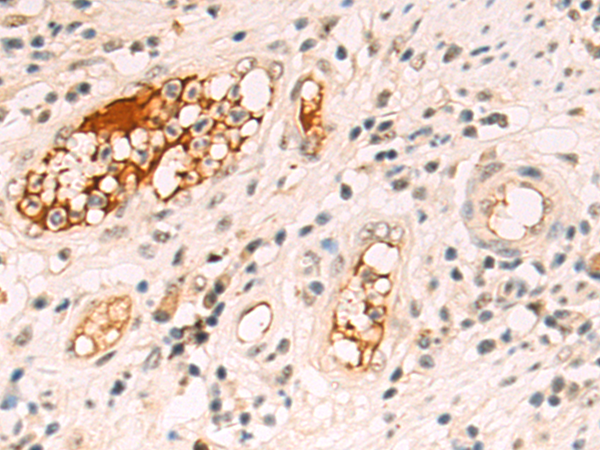

-
分类: 科研抗体货号: P11996别名: NPR2; NPR2L; TUSC4应用: IHC反应种属: Human, Mouse
-
分类: 科研抗体货号: P11995别名: PDCN; SRN1应用: IHC反应种属: Human, Mouse, Rat
-
分类: 科研抗体货号: P12019别名: PAPA; DIPLA1; PAPP-A; PAPPA1; ASBABP2; IGFBP-4ase应用: IHC反应种属: Human, Mouse
-
分类: 科研抗体货号: P11993别名: MOX-2; GP91-3应用: WB,IHC反应种属: Human, Mouse
-
分类: 科研抗体货号: P12001别名: NRIP; ARCAP; IQWD1; PC326; MSTP055; 1200006M05Rik应用: IHC反应种属: Human, Mouse
-
分类: 科研抗体货号: P12018别名: KLS; SRK; S6K2; STK14B; p70S6Kb; P70-beta; S6K-beta2; P70-beta-1; P70-beta-2; p70(S6K)-beta应用: WB,IHC反应种属: Human, Mouse
-
分类: 科研抗体货号: P11992别名: CGD; NOX2; AMCBX2; GP91-1; GP91PHOX; p91-PHOX; GP91-PHOX应用: IHC反应种属: Human, Mouse
-
分类: 科研抗体货号: P11999别名: NS6; CMNS; NCMS; ALPS4; N-ras; NRAS1应用: WB,IHC反应种属: Human, Mouse, Rat
-
分类: 科研抗体货号: P12017别名: P53AIP1应用: IHC反应种属: Human
-
分类: 科研抗体货号: P11991别名: MOX1; NOH1; NOH-1; GP91-2应用: IHC反应种属: Human, Mouse, Rat

鄂公网安备42018502007531号
鄂公网安备42018502007531号

